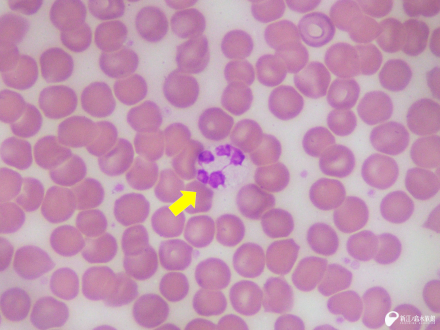

4月16日(木) 体験型展示
「さかなのもぐもぐプール」 リニューアルオープン!
5月 3日(祝・日)、5月 4日(祝・月)、5月 5日(祝・火)は WEBでの入場予約が必要です
新江ノ島水族館 2026年度 実習受け入れについて
カマイルカ「セブン」永眠のご報告

3月14日(土)より 特別イベント『えのすいで発見!!たまごっちと海のなかまたち! 』開催!

新江ノ島水族館と日本大学生物資源科学部における包括的連携協定締結のお知らせ
1月26日(月) 深海Ⅰ ~JAMSTECとの共同研究~ に新水槽がオープン!
飼育歴47年、飼育記録世界一のカマイルカ
「クロス」永眠のご報告
カピバラ「ココロ」「ヒナタ」移動のお知らせ

7月 5日(土) 2年連続!
ミナミアメリカオットセイの赤ちゃん誕生!
今年 2月刊行「江の島むせきつい海岸どうぶつ図鑑」5月13日(火)より無料ダウンロードを開始します!
アオウミガメ「ウチワ」移動のお知らせ
えのすい全館で祝福! 誕生日は“えのすい”へ行こう!
「えのすいハッピーバースデー」
~うれしい誕生日来場特典がいっぱい!~

3月19日(水)より「新江ノ島水族館 × ロマンスカーミュージアム セット券」販売開始!
新江ノ島水族館 デジタル年間パスポート スタート!
今だけもっとお得に!
3月1日(土)より「デジタル会員証スタートキャンペーン」実施します!
2月10日(月)「江の島むせきつい海岸どうぶつ図鑑」刊行のお知らせ

新江ノ島水族館 ご来場 3,000万人達成のご報告
フンボルトペンギン「グー」永眠のお知らせ

「カツオノエボシ」の繁殖の謎に迫る!不思議な生態に新発見!
えのすい公式キャラクター“あわたん”デビュー1周年記念!
待望のLINEスタンプ 4月16日(土)より 販売開始!

新江ノ島水族館 公式LINEスタンプ
「えのすいの生き物たち」好評販売中!
ご来場のみなさま 満足度アンケート実施中
~抽選でオリジナルグッズをプレゼント~
「あつまれ どうぶつの森」の世界で楽しめる!
『えのすい公式マイデザイン』を公開
えのすいecoサポーター好評受付中!えのすいecoを通して、環境活動に参加しませんか。
新江ノ島水族館ホームページへようこそ。